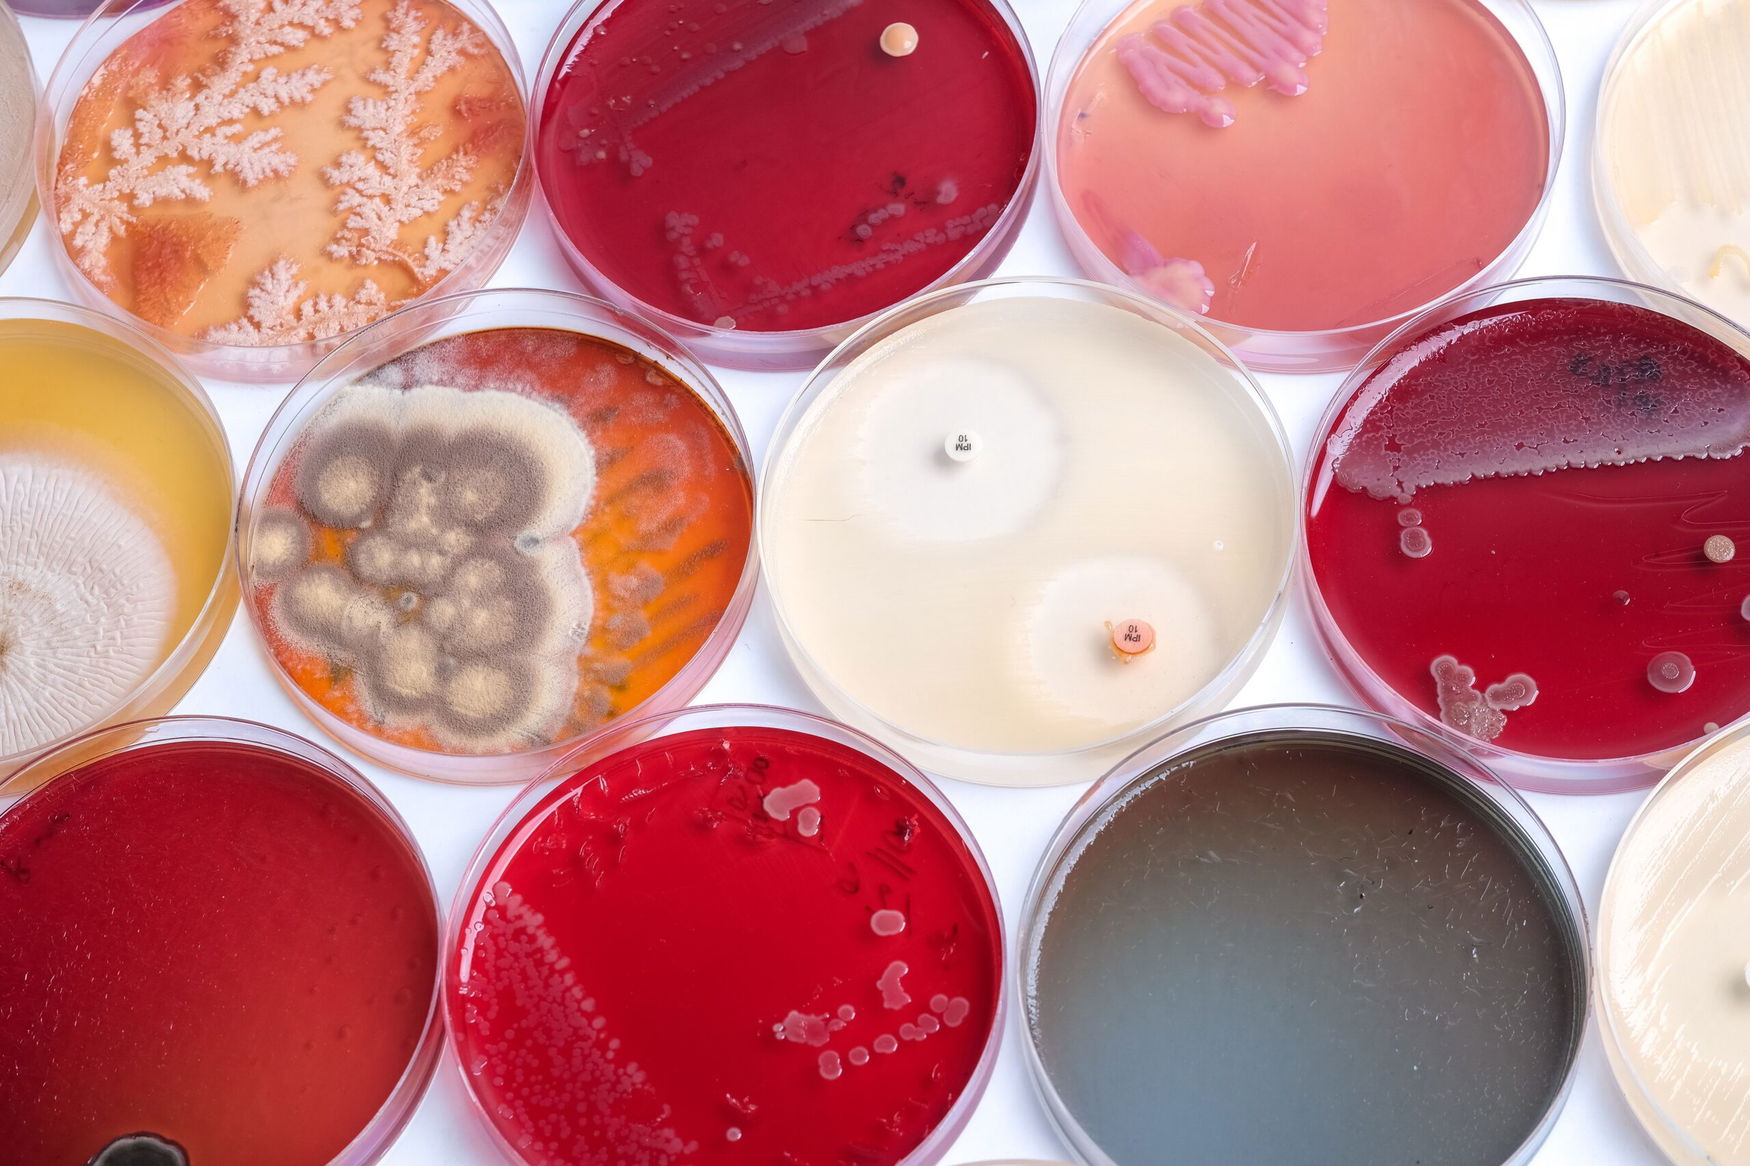
Renaissance BioScience secures Genome BC funding to build yeast discovery platform

Stock quotes
Most read
Events
Live
Stefan Petko
May 6, 06:48 pm
It is alarming to see these developments in California. As a vineyard grower, I have faced significant challenges this year, with fertilizer costs rising sharply while market conditions have made it difficult to sell the harvest.
California peach growers forced to remove 420,000 trees after bankruptcy of Del Monte Foods canneries